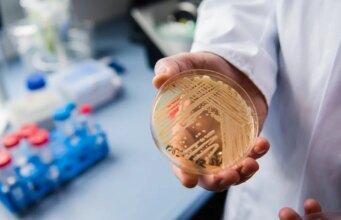
Un “superbatterio” mortale si sta diffondendo negli Stati Uniti man mano che cresce la resistenza ai farmaci, avvertono i ricercatori

Trending Now
FASHION WEEK
Riepilogo dei primi 25: il defunto trey di Jayden Pierre solleva...
10 febbraio 2026; Fort Price, Texas, Stati Uniti; La guardia delle rane cornute della TCU Tanner Toolson (55) e l'attaccante Micah Robinson (5) reagiscono...
GADGET WORLD
BEST Smartphones
Cinque arrestati per omicidio di giovane a Pallavaram
: Giovedì la polizia di Pallavaram ha arrestato cinque persone, tra cui due donne, per l'omicidio di un giovane a Thirusulam.La polizia ha detto...
POPULAR VIDEO
Kim Kardashian e Lewis Hamilton portano in pubblico la loro “storia...
Justin Timberlake espone il seno di Janet Jackson (2004) La più grande rissa nella storia dell'intervallo del Tremendous Bowl...